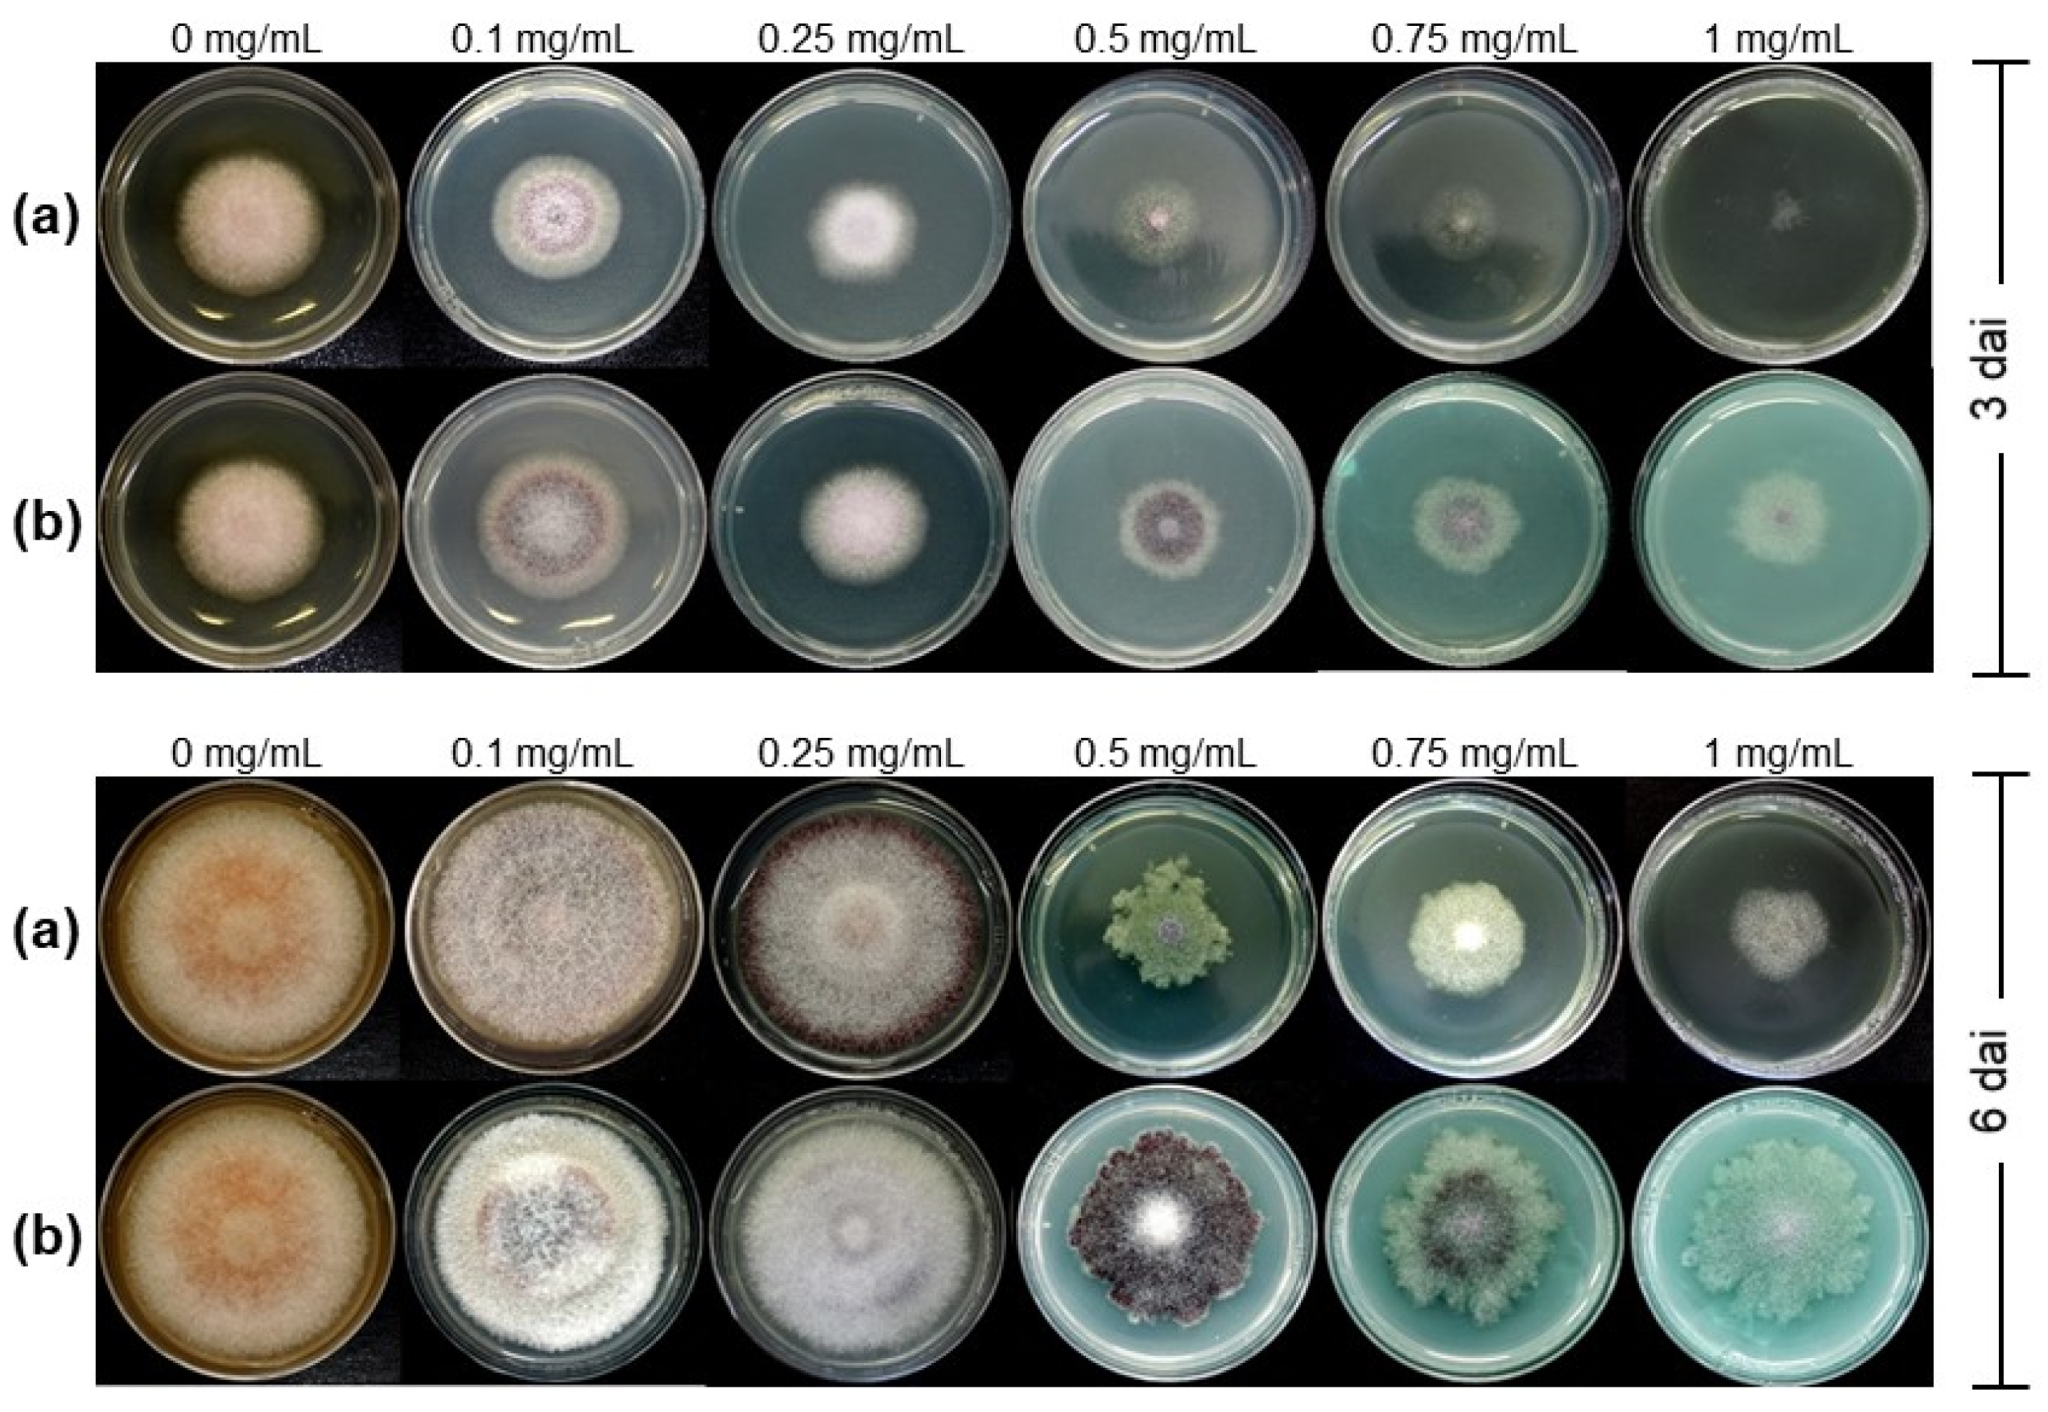

Antifungal Effect of Copper Nanoparticles against Fusarium kuroshium, an Obligate Symbiont of Euwallacea kuroshio Ambrosia Beetle
Abstract
1. Introduction
2. Materials and Methods
2.1. Source of Fungal Symbionts of Ambrosia Beetles, Media, and Culture Conditions
2.2. In Vitro Antifungal Activity Assay
2.3. Analysis of Fungal Morphology through FE-SEM
2.4. RNA Extraction
2.5. RNA-seq Analysis: cDNA Library Preparation and Sequencing
2.6. Data Processing
3. Results
3.1. Antifungal Activity of Cu-NPs on Mycelial Growth
3.2. Analysis of Fungal Morphology through FE-SEM
3.3. Differential Gene Expression of F. kuroshium in Response to Cu-NPs Treatments
3.4. Gene Ontology Enrichment Analysis of Cu-NPs Responsive Genes
3.5. Fusarium kuroshium Genes Involved in Transport, Homeostasis, and Cooper Toxicity and Resistance
4. Discussion
5. Conclusions
Supplementary Materials
Author Contributions
Funding
Data Availability Statement
Acknowledgments
Conflicts of Interest
References
- Kim, S.W.; Jung, J.H.; Lamsal, K.; Kim, Y.S.; Min, J.S.; Lee, Y.S. Antifungal Effects of Silver Nanoparticles (AgNPs) against Various Plant Pathogenic Fungi. Mycobiology 2012, 40, 53–58. [Google Scholar] [CrossRef] [PubMed]
- López-Lorente, Á.I.; Cárdenas, S.; González-Sánchez, Z.I. Effect of synthesis, purification and growth determination methods on the antibacterial and antifungal activity of gold nanoparticles. Mater. Sci. Eng. C Mater. Biol. Appl. 2019, 103, 109805. [Google Scholar] [CrossRef] [PubMed]
- Rekha, R.; Divya, M.; Govindarajan, M.; Alharbi, N.S.; Kadaikunnan, S.; Khaled, J.M.; Al-Anbr, M.N.; Pavela, R.; Vaseeharan, B. Synthesis and characterization of crustin capped titanium dioxide nanoparticles: Photocatalytic, antibacterial, antifungal and insecticidal activities. J. Photochem. Photobiol. B Biol. 2019, 199, 111620. [Google Scholar] [CrossRef] [PubMed]
- Pariona, N.; Paraguay-Delgado, F.; Basurto-Cereceda, S.; Morales-Mendoza, J.E.; Hermida-Montero, L.A.; Mtz-Enriquez, A.I. Shape-dependent antifungal activity of ZnO particles against phytopathogenic fungi. Appl. Nanosci. 2020, 10, 435–443. [Google Scholar] [CrossRef]
- Abd-Elsalam, K.A. Copper Nanostructures: Next-Generation of Agrochemicals for Sustainable Agroecosystems; Elsevier Science: Amsterdam, The Netherlands, 2022. [Google Scholar]
- Gadi, B.; Jeffrey, G. Copper, An Ancient Remedy Returning to Fight Microbial, Fungal and Viral Infections. Curr. Chem. Biol. 2009, 3, 272–278. [Google Scholar] [CrossRef]
- Keller, A.A.; Adeleye, A.S.; Conway, J.R.; Garner, K.L.; Zhao, L.; Cherr, G.N.; Hong, J.; Gardea-Torresdey, J.L.; Godwin, H.A.; Hanna, S.; et al. Comparative environmental fate and toxicity of copper nanomaterials. NanoImpact 2017, 7, 28–40. [Google Scholar] [CrossRef]
- Adam, N.; Vakurov, A.; Knapen, D.; Blust, R. The chronic toxicity of CuO nanoparticles and copper salt to Daphnia magna. J. Hazard. Mater. 2015, 283, 416–422. [Google Scholar] [CrossRef] [PubMed]
- Giannousi, K.; Sarafidis, G.; Mourdikoudis, S.; Pantazaki, A.; Dendrinou-Samara, C. Selective synthesis of Cu₂O and Cu/Cu₂O NPs: Antifungal activity to yeast Saccharomyces cerevisiae and DNA interaction. Inorg. Chem. 2014, 53, 9657–9666. [Google Scholar] [CrossRef]
- Kanhed, P.; Birla, S.; Gaikwad, S.; Gade, A.; Seabra, A.B.; Rubilar, O.; Duran, N.; Rai, M. In vitro antifungal efficacy of copper nanoparticles against selected crop pathogenic fungi. Mater. Lett. 2014, 115, 13–17. [Google Scholar] [CrossRef]
- Hermida-Montero, L.A.; Pariona, N.; Mtz-Enriquez, A.I.; Carrión, G.; Paraguay-Delgado, F.; Rosas-Saito, G. Aqueous-phase synthesis of nanoparticles of copper/copper oxides and their antifungal effect against Fusarium oxysporum. J. Hazard. Mater. 2019, 380, 120850. [Google Scholar] [CrossRef] [PubMed]
- Shen, Y.; Borgatta, J.; Ma, C.; Elmer, W.; Hamers, R.J.; White, J.C. Copper Nanomaterial Morphology and Composition Control Foliar Transfer through the Cuticle and Mediate Resistance to Root Fungal Disease in Tomato (Solanum lycopersicum). J. Agric. Food Chem. 2020, 68, 11327–11338. [Google Scholar] [CrossRef]
- Borgatta, J.; Ma, C.; Hudson-Smith, N.; Elmer, W.; Plaza Pérez, C.D.; De La Torre-Roche, R.; Zuverza-Mena, N.; Haynes, C.L.; White, J.C.; Hamers, R.J. Copper Based Nanomaterials Suppress Root Fungal Disease in Watermelon (Citrullus lanatus): Role of Particle Morphology, Composition and Dissolution Behavior. ACS Sustain. Chem. Eng. 2018, 6, 14847–14856. [Google Scholar] [CrossRef]
- Xiong, L.; Tong, Z.H.; Chen, J.J.; Li, L.L.; Yu, H.Q. Morphology-dependent antimicrobial activity of Cu/CuxO nanoparticles. Ecotoxicology 2015, 24, 2067–2072. [Google Scholar] [CrossRef] [PubMed]
- O′Donnell, K.; Al-Hatmi, A.M.S.; Aoki, T.; Brankovics, B.; Cano-Lira, J.F.; Coleman, J.J.; de Hoog, G.S.; Di Pietro, A.; Frandsen, R.J.N.; Geiser, D.M.; et al. No to Neocosmospora: Phylogenomic and Practical Reasons for Continued Inclusion of the Fusarium solani Species Complex in the Genus Fusarium. Msphere 2020, 5, e00810-20. [Google Scholar] [CrossRef]
- Geiser, D.M.; Al-Hatmi, A.M.S.; Aoki, T.; Arie, T.; Balmas, V.; Barnes, I.; Bergstrom, G.C.; Bhattacharyya, M.K.; Blomquist, C.L.; Bowden, R.L.; et al. Phylogenomic Analysis of a 55.1-kb 19-Gene Dataset Resolves a Monophyletic Fusarium that Includes the Fusarium solani Species Complex. Phytopathology 2021, 111, 1064–1079. [Google Scholar] [CrossRef] [PubMed]
- Na, F.; Carrillo, J.D.; Mayorquin, J.S.; Ndinga-Muniania, C.; Stajich, J.E.; Stouthamer, R.; Huang, Y.-T.; Lin, Y.-T.; Chen, C.Y.; Eskalen, A. Two novel fungal symbionts Fusarium kuroshium sp. nov. and Graphium kuroshium sp. nov. of Kuroshio shot hole borer (Euwallacea sp. nr. fornicatus) cause Fusarium dieback on woody host species in California. Plant Dis. 2018, 102, 1154–1164. [Google Scholar] [CrossRef] [PubMed]
- García-Avila, C.D.J.; Trujillo-Arriaga, F.J.; López-Buenfil, J.A.; González-Gómez, R.; Carrillo, D.; Cruz, L.F.; Ruiz-Galván, I.; Quezada-Salinas, A.; Acevedo-Reyes, N. First Report of Euwallacea nr. fornicatus (Coleoptera: Curculionidae) in Mexico. Fla. Entomol. 2016, 99, 555–556. [Google Scholar] [CrossRef]
- Pérez-Torres, C.A.; Ibarra-Laclette, E.; Hernández-Domínguez, E.E.; Rodríguez-Haas, B.; Pérez-Lira, A.J.; Villafán, E.; Alonso-Sánchez, A.; García-Ávila, C.J.; Ramírez-Pool, J.A.; Sánchez-Rangel, D. Molecular evidence of the avocado defense response to Fusarium kuroshium infection: A deep transcriptome analysis using RNA-Seq. PeerJ 2021, 9, e11215. [Google Scholar] [CrossRef] [PubMed]
- Boland, J.M. The impact of an invasive ambrosia beetle on the riparian habitats of the Tijuana River Valley, California. PeerJ 2016, 4, e2141. [Google Scholar] [CrossRef]
- Eskalen, A.; Stouthamer, R.; Lynch, S.C.; Rugman-Jones, P.F.; Twizeyimana, M.; Gonzalez, A.; Thibault, T. Host Range of Fusarium Dieback and Its Ambrosia Beetle (Coleoptera: Scolytinae) Vector in Southern California. Plant Dis. 2013, 97, 938–951. [Google Scholar] [CrossRef] [PubMed]
- Freeman, S.; Sharon, M.; Maymon, M.; Mendel, Z.; Protasov, A.; Aoki, T.; Eskalen, A.; O’Donnell, K. Fusarium euwallaceae sp. nov.--a symbiotic fungus of Euwallacea sp., an invasive ambrosia beetle in Israel and California. Mycologia 2013, 105, 1595–1606. [Google Scholar] [CrossRef]
- Eskalen, A. Invasive Shot Hole Borers. Available online: https://sdmmp.com/upload/SDMMP_Repository/0/rzxynghs6qc2vtw57mdbk9p018j4f3.pdf (accessed on 10 February 2022).
- Mayorquin, J.S.; Carrillo, J.D.; Twizeyimana, M.; Peacock, B.B.; Sugino, K.Y.; Na, F.; Wang, D.H.; Kabashima, J.N.; Eskalen, A. Chemical Management of Invasive shot hole borer and Fusarium Dieback in California sycamore (Platanus racemosa) in Southern California. Plant Dis. 2018, 102, 1307–1315. [Google Scholar] [CrossRef] [PubMed]
- Ibarra-Laclette, E.; Sánchez-Rangel, D.; Hernández-Domínguez, E.; Pérez-Torres, C.A.; Ortiz-Castro, R.; Villafán, E.; Alonso-Sánchez, A.; Rodríguez-Hass, B.; López-Buenfil, A.; García-Avila, C.; et al. Draft Genome Sequence of the Phytopathogenic Fungus Fusarium euwallaceae, the Causal Agent of Fusarium Dieback. Genome Announc. 2017, 5, e00881-17. [Google Scholar] [CrossRef] [PubMed]
- Sánchez-Rangel, D.; Hernandez-Dominguez, E.E.; Perez-Torres, C.A.; Ortiz-Castro, R.; Villafan, E.; Rodriguez-Haas, B.; Alonso-Sanchez, A.; Lopez-Buenfil, A.; Carrillo-Ortiz, N.; Hernandez-Ramos, L.; et al. Environmental pH modulates transcriptomic responses in the fungus Fusarium sp. associated with KSHB Euwallacea sp. near fornicatus. BMC Genom. 2018, 19, 721. [Google Scholar] [CrossRef] [PubMed]
- Pariona, N.; Mtz-Enriquez, A.I.; Sánchez-Rangel, D.; Carrión, G.; Paraguay-Delgado, F.; Rosas-Saito, G. Green-synthesized copper nanoparticles as a potential antifungal against plant pathogens. RSC Adv. 2019, 9, 18835–18843. [Google Scholar] [CrossRef]
- Balouiri, M.; Sadiki, M.; Ibnsouda, S.K. Methods for in vitro evaluating antimicrobial activity: A review. J. Pharm. analysis 2016, 6, 71–79. [Google Scholar] [CrossRef]
- Bozzola, J.J.; Russell, L.D. Electron Microscopy: Principles and Techniques for Biologists; Jones and Bartlett: Boston, MA, USA, 1999. [Google Scholar]
- Bolger, A.M.; Lohse, M.; Usadel, B. Trimmomatic: A flexible trimmer for Illumina sequence data. Bioinformatics 2014, 30. [Google Scholar] [CrossRef] [PubMed]
- Langmead, B.; Salzberg, S.L. Fast gapped-read alignment with Bowtie 2. Nat. Methods 2012, 9, 357–359. [Google Scholar] [CrossRef] [PubMed]
- Li, B.; Dewey, C.N. RSEM: Accurate transcript quantification from RNA-Seq data with or without a reference genome. BMC Bioinform. 2011, 12, 323. [Google Scholar] [CrossRef]
- Wagner, G.P.; Kin, K.; Lynch, V.J. Measurement of mRNA abundance using RNA-seq data: RPKM measure is inconsistent among samples. Theory Biosci. 2012, 131, 281–285. [Google Scholar] [CrossRef]
- Love, M.I.; Huber, W.; Anders, S. Moderated estimation of fold change and dispersion for RNA-seq data with DESeq2. Genome Biol. 2014, 15, 550. [Google Scholar] [CrossRef] [PubMed]
- Ashburner, M.; Ball, C.A.; Blake, J.A.; Botstein, D.; Butler, H.; Cherry, J.M.; Davis, A.P.; Dolinski, K.; Dwight, S.S.; Eppig, J.T.; et al. Gene ontology: Tool for the unification of biology. The Gene Ontology Consortium. Nat. Genet. 2000, 25, 25–29. [Google Scholar] [CrossRef] [PubMed]
- Barrett, A.J. Nomenclature Committee of the International Union of Biochemistry and Molecular Biology (NC-IUBMB). Enzyme Nomenclature. Recommendations 1992. Supplement 4: Corrections and additions (1997). Eur. J. Biochem. 1997, 250, 1–6. [Google Scholar] [CrossRef] [PubMed]
- Kanehisa, M.; Sato, Y.; Kawashima, M.; Furumichi, M.; Tanabe, M. KEGG as a reference resource for gene and protein annotation. Nucleic Acids Res. 2016, 44, D457–D462. [Google Scholar] [CrossRef] [PubMed]
- Jones, P.; Binns, D.; Chang, H.Y.; Fraser, M.; Li, W.; McAnulla, C.; McWilliam, H.; Maslen, J.; Mitchell, A.; Nuka, G.; et al. InterProScan 5: Genome-scale protein function classification. Bioinformatics 2014, 30, 1236–1240. [Google Scholar] [CrossRef]
- Finn, R.D.; Attwood, T.K.; Babbitt, P.C.; Bateman, A.; Bork, P.; Bridge, A.J.; Chang, H.-Y.; Dosztányi, Z.; El-Gebali, S.; Fraser, M.; et al. InterPro in 2017—beyond protein family and domain annotations. Nucleic Acids Research 2017, 45, D190–D199. [Google Scholar] [CrossRef]
- Raudvere, U.; Kolberg, L.; Kuzmin, I.; Arak, T.; Adler, P.; Peterson, H.; Vilo, J. g:Profiler: A web server for functional enrichment analysis and conversions of gene lists (2019 update). Nucleic Acids Res. 2019, 47, W191–W198. [Google Scholar] [CrossRef] [PubMed]
- Robinson, J.R.; Isikhuemhen, O.S.; Anike, F.N. Fungal-Metal Interactions: A Review of Toxicity and Homeostasis. J. Fungi 2021, 7, 225. [Google Scholar] [CrossRef] [PubMed]
- Ren, M.; Li, R.; Han, B.; You, Y.; Huang, W.; Du, G.; Zhan, J. Involvement of the High-Osmolarity Glycerol Pathway of Saccharomyces Cerevisiae in Protection against Copper Toxicity. Antioxidants 2022, 11, 200. [Google Scholar] [CrossRef] [PubMed]
- Jo, W.J.; Loguinov, A.; Chang, M.; Wintz, H.; Nislow, C.; Arkin, A.P.; Giaever, G.; Vulpe, C.D. Identification of genes involved in the toxic response of Saccharomyces cerevisiae against iron and copper overload by parallel analysis of deletion mutants. Toxicol. Sci. Off. J. Soc. Toxicol. 2008, 101, 140–151. [Google Scholar] [CrossRef] [PubMed]
- Dong, K.; Addinall, S.G.; Lydall, D.; Rutherford, J.C. The yeast copper response is regulated by DNA damage. Mol. Cell Biol. 2013, 33, 4041–4050. [Google Scholar] [CrossRef] [PubMed]
- Oc, S.; Eraslan, S.; Kirdar, B. Dynamic transcriptional response of Saccharomyces cerevisiae cells to copper. Sci. Rep. 2020, 10, 18487. [Google Scholar] [CrossRef]
- Yasokawa, D.; Murata, S.; Kitagawa, E.; Iwahashi, Y.; Nakagawa, R.; Hashido, T.; Iwahashi, H. Mechanisms of copper toxicity in Saccharomyces cerevisiae determined by microarray analysis. Environ. Toxicol. 2008, 23, 599–606. [Google Scholar] [CrossRef] [PubMed]
- Georgatsou, E.; Alexandraki, D. Two distinctly regulated genes are required for ferric reduction, the first step of iron uptake in Saccharomyces cerevisiae. Mol. Cell Biol. 1994, 14, 3065–3073. [Google Scholar] [CrossRef]
- Hassett, R.; Kosman, D.J. Evidence for Cu(II) reduction as a component of copper uptake by Saccharomyces cerevisiae. J. Biol. Chem. 1995, 270, 128–134. [Google Scholar] [CrossRef] [PubMed]
- Yamaguchi-Iwai, Y.; Dancis, A.; Klausner, R.D. AFT1: A mediator of iron regulated transcriptional control in Saccharomyces cerevisiae. Embo J. 1995, 14, 1231–1239. [Google Scholar] [CrossRef] [PubMed]
- Georgatsou, E.; Mavrogiannis, L.A.; Fragiadakis, G.S.; Alexandraki, D. The yeast Fre1p/Fre2p cupric reductases facilitate copper uptake and are regulated by the copper-modulated Mac1p activator. J. Biol. Chem. 1997, 272, 13786–13792. [Google Scholar] [CrossRef] [PubMed]
- Beaudoin, J.; Ekici, S.; Daldal, F.; Ait-Mohand, S.; Guérin, B.; Labbé, S. Copper transport and regulation in Schizosaccharomyces pombe. Biochem. Soc. Trans. 2013, 41, 1679–1686. [Google Scholar] [CrossRef] [PubMed][Green Version]
- Yuan, D.S.; Dancis, A.; Klausner, R.D. Restriction of copper export in Saccharomyces cerevisiae to a late Golgi or post-Golgi compartment in the secretory pathway. J. Biol. Chem. 1997, 272, 25787–25793. [Google Scholar] [CrossRef]
- Vest, K.E.; Leary, S.C.; Winge, D.R.; Cobine, P.A. Copper import into the mitochondrial matrix in Saccharomyces cerevisiae is mediated by Pic2, a mitochondrial carrier family protein. J. Biol. Chem. 2013, 288, 23884–23892. [Google Scholar] [CrossRef]
- De Silva, D.M.; Askwith, C.C.; Eide, D.; Kaplan, J. The FET3 gene product required for high affinity iron transport in yeast is a cell surface ferroxidase. J. Biol. Chem. 1995, 270, 1098–1101. [Google Scholar] [CrossRef]
- Wiemann, P.; Perevitsky, A.; Lim, F.Y.; Shadkchan, Y.; Knox, B.P.; Landero Figueora, J.A.; Choera, T.; Niu, M.; Steinberger, A.J.; Wüthrich, M.; et al. Aspergillus fumigatus Copper Export Machinery and Reactive Oxygen Intermediate Defense Counter Host Copper-Mediated Oxidative Antimicrobial Offense. Cell Rep. 2017, 19, 1008–1021. [Google Scholar] [CrossRef]
- Cheong, Y.K.; Arce, M.P.; Benito, A.; Chen, D.; Luengo Crisóstomo, N.; Kerai, L.V.; Rodríguez, G.; Valverde, J.L.; Vadalia, M.; Cerpa-Naranjo, A.; et al. Synergistic Antifungal Study of PEGylated Graphene Oxides and Copper Nanoparticles against Candida albicans. Nanomaterials 2020, 10, 819. [Google Scholar] [CrossRef] [PubMed]
- Dunkel, N.; Liu, T.T.; Barker, K.S.; Homayouni, R.; Morschhäuser, J.; Rogers, P.D. A gain-of-function mutation in the transcription factor Upc2p causes upregulation of ergosterol biosynthesis genes and increased fluconazole resistance in a clinical Candida albicans isolate. Eukaryot. Cell 2008, 7, 1180–1190. [Google Scholar] [CrossRef] [PubMed]
- MacPherson, S.; Akache, B.; Weber, S.; De Deken, X.; Raymond, M.; Turcotte, B. Candida albicans zinc cluster protein Upc2p confers resistance to antifungal drugs and is an activator of ergosterol biosynthetic genes. Antimicrob. Agents Chemother. 2005, 49, 1745–1752. [Google Scholar] [CrossRef] [PubMed]
- Jyothi Lekshmi, O.B.; Amrutha, P.R.; Jeeva, M.L.; Asha Devi, A.; Veena, S.S.; Sreelatha, G.L.; Sujina, M.G.; Syriac, T. Development of an Efficient Real-time PCR Assay to Accurately Quantify Resistant Gene Analogue Expression in Taro (Colocasia esculenta). J. Root Crop. 2020, 44, 3–11. [Google Scholar]
- Wang, R.; Ma, P.; Li, C.; Xiao, L.; Liang, Z.; Dong, J. Combining transcriptomics and metabolomics to reveal the underlying molecular mechanism of ergosterol biosynthesis during the fruiting process of Flammulina velutipes. BMC Genom. 2019, 20, 999. [Google Scholar] [CrossRef] [PubMed]
- Veen, M.; Stahl, U.; Lang, C. Combined overexpression of genes of the ergosterol biosynthetic pathway leads to accumulation of sterols in Saccharomyces cerevisiae. FEMS Yeast Res. 2003, 4, 87–95. [Google Scholar] [CrossRef]
- Thabet, S.; Simonet, F.; Lemaire, M.; Guillard, C.; Cotton, P. Impact of photocatalysis on fungal cells: Depiction of cellular and molecular effects on Saccharomyces cerevisiae. Appl. Environ. Microbiol. 2014, 80, 7527–7535. [Google Scholar] [CrossRef]
- Cordero, R.J.; Casadevall, A. Functions of fungal melanin beyond virulence. Fungal Biol. Rev. 2017, 31, 99–112. [Google Scholar] [CrossRef] [PubMed]
- Dutton, M.V.; Evans, C.S. Oxalate production by fungi: Its role in pathogenicity and ecology in the soil environment. Can. J. Microbiol. 1996, 42, 881–895. [Google Scholar] [CrossRef]
- Jones, D.L. Organic acids in the rhizosphere—A critical review. Plant Soil 1998, 205, 25–44. [Google Scholar] [CrossRef]
- Liaud, N.; Giniés, C.; Navarro, D.; Fabre, N.; Crapart, S.; Gimbert, I.H.; Levasseur, A.; Raouche, S.; Sigoillot, J.-C. Exploring fungal biodiversity: Organic acid production by 66 strains of filamentous fungi. Fungal Biol. Biotechnol. 2014, 1, 1. [Google Scholar] [CrossRef]
- Tanaka, N.; Akamatsu, Y.; Hattori, T.; Shimada, M.J.W.R. Effect of Oxalic Acid on the Oxidative Breakdown of Cellulose by the Fenton Reaction. Wood Res. Bull. Wood Res. Inst. Kyoto Univ. 1994, 81, 8–10. [Google Scholar]
- Shimada, M.; Akamtsu, Y.; Tokimatsu, T.; Mii, K.; Hattori, T. Possible biochemical roles of oxalic acid as a low molecular weight compound involved in brown-rot and white-rot wood decays. J. Biotechnol. 1997, 53, 103–113. [Google Scholar] [CrossRef]
- Green, F.; Highley, T.L. Mechanism of brown-rot decay: Paradigm or paradox. Int. Biodeterior. Biodegrad. 1997, 39, 113–124. [Google Scholar] [CrossRef]
- Galván Márquez, I.; Ghiyasvand, M.; Massarsky, A.; Babu, M.; Samanfar, B.; Omidi, K.; Moon, T.W.; Smith, M.L.; Golshani, A. Zinc oxide and silver nanoparticles toxicity in the baker’s yeast, Saccharomyces cerevisiae. PLoS ONE 2018, 13, e0193111. [Google Scholar] [CrossRef]
- Horstmann, C.; Campbell, C.; Kim, D.S.; Kim, K. Transcriptome profile with 20 nm silver nanoparticles in yeast. FEMS Yeast Res. 2019, 19. [Google Scholar] [CrossRef]
- Das, D.; Ahmed, G. Silver nanoparticles damage yeast cell wall. J. Biotechnol. 2012, 3, 36–39. [Google Scholar]
- Butt, T.R.; Sternberg, E.; Herd, J.; Crooke, S.T. Cloning and expression of a yeast copper metallothionein gene. Gene 1984, 27, 23–33. [Google Scholar] [CrossRef]
- Christen, S.; Peterhans, E.; Stocker, R. Antioxidant activities of some tryptophan metabolites: Possible implication for inflammatory diseases. Proc. Natl. Acad. Sci. USA 1990, 87, 2506–2510. [Google Scholar] [CrossRef] [PubMed]
- Hayaishi, O.; Hirata, F.; Ohnishi, T.; Henry, J.P.; Rosenthal, I.; Katoh, A. INDOLEAMINE 2,3-DIOXYGENASE—INCORPORATION OF (02)-0-18- AND (02)-0-18 INTO REACTION-PRODUCTS. J. Biol. Chem. 1977, 252, 3548–3550. [Google Scholar] [CrossRef]
- Antsotegi-Uskola, M.; Markina-Iñarrairaegui, A.; Ugalde, U. Copper Resistance in Aspergillus nidulans Relies on the P(I)-Type ATPase CrpA, Regulated by the Transcription Factor AceA. Front. Microbiol. 2017, 8, 912. [Google Scholar] [CrossRef] [PubMed]
- Sharon, A.; Finkelstein, A.; Shlezinger, N.; Hatam, I. Fungal apoptosis: Function, genes and gene function. FEMS Microbiol. Rev. 2009, 33, 833–854. [Google Scholar] [CrossRef] [PubMed]

Publisher’s Note: MDPI stays neutral with regard to jurisdictional claims in published maps and institutional affiliations. |
© 2022 by the authors. Licensee MDPI, Basel, Switzerland. This article is an open access article distributed under the terms and conditions of the Creative Commons Attribution (CC BY) license (https://creativecommons.org/licenses/by/4.0/).
Share and Cite
Ibarra-Laclette, E.; Blaz, J.; Pérez-Torres, C.-A.; Villafán, E.; Lamelas, A.; Rosas-Saito, G.; Ibarra-Juárez, L.A.; García-Ávila, C.d.J.; Martínez-Enriquez, A.I.; Pariona, N. Antifungal Effect of Copper Nanoparticles against Fusarium kuroshium, an Obligate Symbiont of Euwallacea kuroshio Ambrosia Beetle. J. Fungi 2022, 8, 347. https://doi.org/10.3390/jof8040347
Ibarra-Laclette E, Blaz J, Pérez-Torres C-A, Villafán E, Lamelas A, Rosas-Saito G, Ibarra-Juárez LA, García-Ávila CdJ, Martínez-Enriquez AI, Pariona N. Antifungal Effect of Copper Nanoparticles against Fusarium kuroshium, an Obligate Symbiont of Euwallacea kuroshio Ambrosia Beetle. Journal of Fungi. 2022; 8(4):347. https://doi.org/10.3390/jof8040347
Chicago/Turabian StyleIbarra-Laclette, Enrique, Jazmín Blaz, Claudia-Anahí Pérez-Torres, Emanuel Villafán, Araceli Lamelas, Greta Rosas-Saito, Luis Arturo Ibarra-Juárez, Clemente de Jesús García-Ávila, Arturo Isaías Martínez-Enriquez, and Nicolaza Pariona. 2022. "Antifungal Effect of Copper Nanoparticles against Fusarium kuroshium, an Obligate Symbiont of Euwallacea kuroshio Ambrosia Beetle" Journal of Fungi 8, no. 4: 347. https://doi.org/10.3390/jof8040347
APA StyleIbarra-Laclette, E., Blaz, J., Pérez-Torres, C.-A., Villafán, E., Lamelas, A., Rosas-Saito, G., Ibarra-Juárez, L. A., García-Ávila, C. d. J., Martínez-Enriquez, A. I., & Pariona, N. (2022). Antifungal Effect of Copper Nanoparticles against Fusarium kuroshium, an Obligate Symbiont of Euwallacea kuroshio Ambrosia Beetle. Journal of Fungi, 8(4), 347. https://doi.org/10.3390/jof8040347

